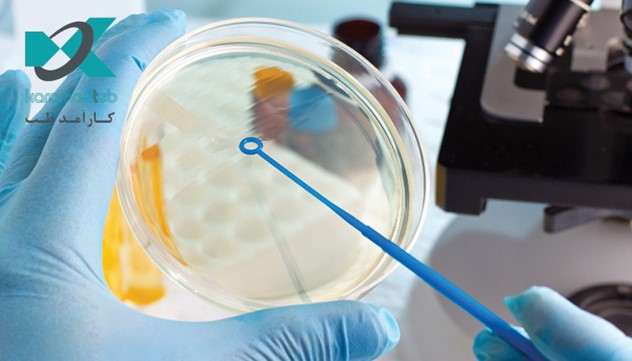
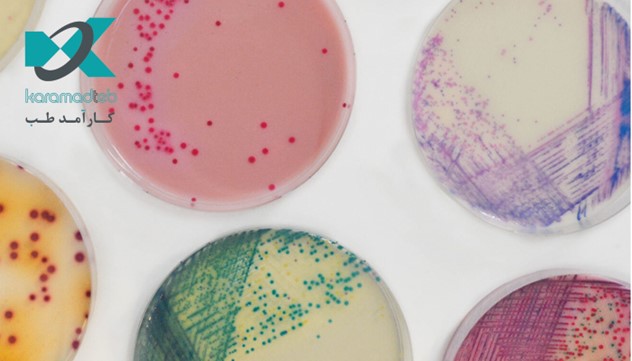
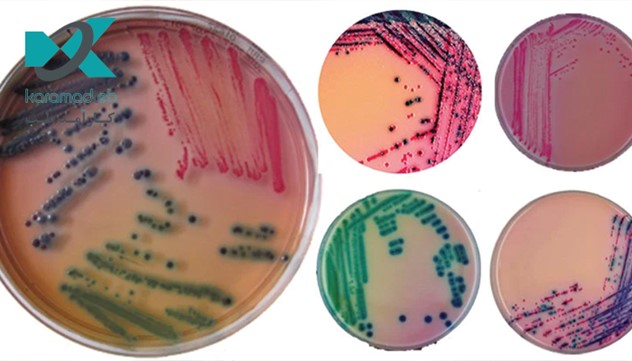
محیط کشت کروم آگار و مزایای آن

محیط کشت کروم آگار به تکنسین ها اجازه می دهد تا بر نمونه های آلوده واقعی تمرکز کنند و با یک نگاه از رنگ شان آن ها را را تشخیص دهند.
دکتر رامباخ نخستین محیط کشت کروموژنیک به منظور تشخیص E.coli را در سال 1979 اختراع و ثبت کرد. فناوری کروم آگار یک روش تمایز مبتنی بر رنگ، بر اساس مولکول های بی رنگ محلول (به نام کروموژن) است که از یک بستر و یک کروموفور تشکیل شده است.
هنگامی که آنزیم ارگانیسم هدف، مزدوج کروموژنیک بی رنگ را می شکافد، کروموفور آزاد می شود. کروموفور در شکل غیر کونژوگه خود، رنگ متمایز نشان می دهد و به دلیل کاهش حلالیت، یک رسوب تشکیل می دهد. نتیجه بسیار خاص است و به وضوح با چشم غیر مسلح در شرایط نوری معمولی قابل تشخیص می باشد.
با این تکنیک، کلنی های میکروارگانیسم های خاص را می توان با یک نگاه از رنگ آن ها تشخیص داد. رامباخ آگار اکثر موارد مثبت کاذب را حذف می کند و به تکنسین ها اجازه می دهد تا بر روی نمونه های آلوده واقعی تمرکز کنند.
در این مطلب به نحوه کار محیط کشت کروماگار و مزایای آن می پردازیم.
فناوری کروم آگار چگونه کار می کند؟
قدرت فناوری کروموژنیک ترکیبی از تشخیص فعالیت دقیق آنزیم و رنگ آمیزی موضعی است. این در کلنی رسوب می کند و به لطف رنگ بندی باکتری های رشد یافته امکان تمایز آسان میکروارگانیسم ها را فراهم می سازد.
همان گون که اشاره شد، این فناوری مبتنی بر مولکول بی رنگ محلول به نام کروموژن است که از یک بستر تشکیل شده است که یک فعالیت آنزیمی خاص و یک کروموفور را هدف قرار می دهد.
هنگامی که آنزیم ارگانیسم هدف، مزدوج کروموژنیک بی رنگ را می شکافد، کروموفور آزاد می شود..کروموفور در شکل غیر کونژوگه خود، رنگ متمایز خود را نشان داده و به دلیل کاهش حلالیت، یک رسوب تشکیل می دهد.
نتیجه یک تمایز مبتنی بر رنگ بسیار خاص و متمایز است که به وضوح با چشم غیر مسلح در شرایط نور طبیعی قابل تشخیص است.
تهیه محیط کروم اگار
- اجزا را به آب مقطر/دیونیزه اضافه کنید و حجم را به 1.0 لیتر برسانید.
- کاملا مخلوط کنید.
- در یک حمام آب جوش یا در جریان بخار گرم کنید، در حالی که هر از گاهی تکان دهید.
- اگر هیچ ذره بصری به دیوار شیشه ای نچسبد، محیط کاملا معلق می شود.
- محیط نباید بیشتر تحت عملیات حرارتی قرار گیرد.
- انحلال کامل با تکان دادن در توالی های 5 دقیقه ای تقریبا 35 تا 40 دقیقه است.
- اتوکلاو نکنید.بیش از حد گرم نکنید.
- هر چند وقت یک بار به آرامی تکان دهید و تا حد امکان تا 45-50 درجه سانتی گراد خنک کنید.
- در ظروف پتری استریل بریزید.
- برای جلوگیری از رسوب یا لخته شدن مخلوط کروموژنیک در صفحه ها، ظروف پتری را در حین ریختن روی سطح خنک (حداکثر 25 درجه سانتی گراد) قرار دهید.
- صفحه ها مات و صورتی هستند.
موارد استفاده از این محیط کشت
- برای متمایز کردن موجودات بر اساس کلنی های رنگی خاص.
- این یک محیط کشت افتراقی-تشخیصی برای شناسایی انواع ارگانیسم ها در مواد غذایی و نمونه های بالینی است.
- کروم آگار به عنوان یک آگار مکمل در آزمایش مواد غذایی برایسالمونلا پتانسیل دارد
- تشخیص سریعکلستریدیوم پرفرنجنس،لیستریا مونوسیتوژنز، باسیلوس سرئوس و استافیلوکوکوس اورئوس. همچنین دارای کاربردهای اضافی روش های تشخیص آنزیم در میکروبیولوژی غذا و آب توسط محیط آگار کروموژنیک است .
مزایای این روش چیست؟
فناوری کروم آگار ابزاری قدرتمند برای تشخیص میکروارگانیسم های هدف حتی در شرایط کشت مخلوط است که به کاربر این امکانات را می دهد:
– تشخیص فنوتیپی، یعنی بر اساس الگوی بیان شده توسط میکروارگانیسم
– تشخیص بالای جمعیت ماینر: استفاده مناسب از جهت گیری کروم آگار به درستی حضور یک جمعیت جزئی را مشخص کرده و به ایجاد تشخیص و درمان صحیح کمک می کند.
– پالت رنگی فوری برای به دست آوردن طیف وسیعی از تمایز گونه ها:
– جهت گیری CHROMagar دارای چندین مزیت نسبت به رسانه های سنتی است:
- در بیشتر موارد امکان تمایز کامل عوامل بیماری زا را فراهم می کند.
- امکان ارزیابی نیمه کمی و شناسایی احتمالی پاتوژن های دستگاه ادراری را فراهم می کند.
- امکان تشخیص آسان تر رشد مخلوط را فراهم می کند.
- نرخ تشخیص بالاتری را فراهم می کند.
– تسهیل شناسایی نهایی (بدون خرده فرهنگ، تعداد کلنی های کمتر برای آزمایش)
– نتیجه سریع تر و کارآمدتر
– روش تمایز مبتنی بر رنگ
– خواندن نتایج با چشم به لطف رنگ های منحصر به فرد. با استفاده از این تکنیک، کلنی های میکروارگانیسم های خاص را می توان با یک نگاه از رنگ آن ها تشخیص داد و خطر تفسیر نادرست را محدود می کند.
– صرفه جویی در مقیاس: صرفه جویی در هزینه و روش سریع!
– امکان تمایز آسان میکروارگانیسم ها را بدون روش های پیچیده و پرهزینه تشخیص سنتی که در تکنیک های آزمایش آگار سنتی به کار می رود (بدون خرده کشت).
– با صرفه جویی در زمان و کار، کارایی تست های آزمایشگاهی را افزایش می دهد.
– با کوتاه کردن بازه زمانی شناسایی عوامل بیماری زا، به جلوگیری از گسترش عفونت ها کمک می کند.
آینده آگار کروموژنیک
رامباخ همچنان نقش اصلی را در مدیریت، تحقیق و توسعه محصولات کروم آگار ایفا می کند . این شرکت با داشتن بیش از 50 درصد کارکنان محقق و متعهد به دنبال علم با کیفیت است . ماموریت فعلی سازمان یافتن راه حل های تشخیص و شناسایی سریع برای چالش های اصلی کنترل عفونت، مانند باکتری های مقاوم به چند دارو است.
رامباخ نمونه ای از این است که چگونه داشتن عزم و اشتیاق کافی برای یک موضوع، به علاوه پشتکار، ممکن است به شما کمک کند دنیا را تغییر دهید.
سخن آخر
در این مطلب به بررسی محیط کشت کروم آگار، نحوه کار و مزایای این فناوری پرداختیم. شما عزیزان می توانید برای کسب اطلاعات بیشتر در زمینه محیط کشت کروم آگار با کارشناسان وب سایت کارآمد طب در ارتباط باشید.
شرکت کارآمد طب در زمینه فروش مواد و تجهیزات آزمایشگاهی، نیز ارائه خدمات حوزه های محیط های کشت میکروب شناسی با قیمت مقرون به صرفه فعال می باشد.